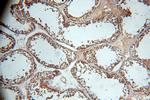
WDR1 Antibody in Immunohistochemistry (Paraffin) (IHC (P))

Search
Proteintech
WDR1 Polyclonal Antibody
{{$productOrderCtrl.translations['antibody.pdp.commerceCard.promotion.promotions']}}
{{$productOrderCtrl.translations['antibody.pdp.commerceCard.promotion.viewpromo']}}
{{$productOrderCtrl.translations['antibody.pdp.commerceCard.promotion.promocode']}}: {{promo.promoCode}} {{promo.promoTitle}} {{promo.promoDescription}}. {{$productOrderCtrl.translations['antibody.pdp.commerceCard.promotion.learnmore']}}
产品信息
13676-1-AP
种属反应
已发表种属
宿主/亚型
分类
类型
抗原
偶联物
形式
浓度
规格
纯化类型
保存液
内含物
保存条件
运输条件
产品详细信息
Immunogen sequence: MPYEIKKVF ASLPQVERGV SKIIGGDPKG NNFLYTNGKC VILRNIDDHS RFVNCVRFSP DGNRFATASA DGQIYIYDGK TGEKVCALGG SKAHDGGIYA ISWSPDSTHL LSASGDKTSK IWDVSVNSVV STFPMGSTVL DQQLGCLWQK DHLLSVSLSG YINYLDRNNP SKPLHVIKGH SKSIQCLTVH KNGGKSYIYS GSHDGHINYW DSETGENDSF AGKGHTNQVS RMTVDESGQL ISCSMDDTVR YTSLMLRDYS GQGVVKLDVQ PKCVAVGPGG YAVVVCIGQI VLLKDQRKCF SIDNPGYEPE VVAVHPGGDT VAIGGVDGNV RLYSILGTTL KDEGKLLEAK G (1-350 aa encoded by BC030541)
靶标信息
This gene encodes a protein containing 9 WD repeats. WD repeats are approximately 30- to 40-amino acid domains containing several conserved residues, mostly including a trp-asp at the C-terminal end. WD domains are involved in protein-protein interactions. The encoded protein may help induce the disassembly of actin filaments. Two transcript variants encoding different isoforms have been found for this gene.
仅用于科研。不用于诊断过程。未经明确授权不得转售。
生物信息学
蛋白别名: Actin-interacting protein 1; AIP1; contains WD40 repeats; epididymis secretory protein Li 52; NB4 apoptosis related protein; NORI-1; unnamed protein product; WD repeat protein 1; WD repeat-containing protein 1; WD40 repeat protein 1; WD40 repeats
基因别名: AIP1; D5Wsu185e; HEL-S-52; NORI-1; PFITS; rede; WDR1
UniProt ID: (Human) O75083, (Rat) Q5RKI0, (Mouse) O88342
Entrez Gene ID: (Human) 9948, (Rat) 360950, (Mouse) 22388